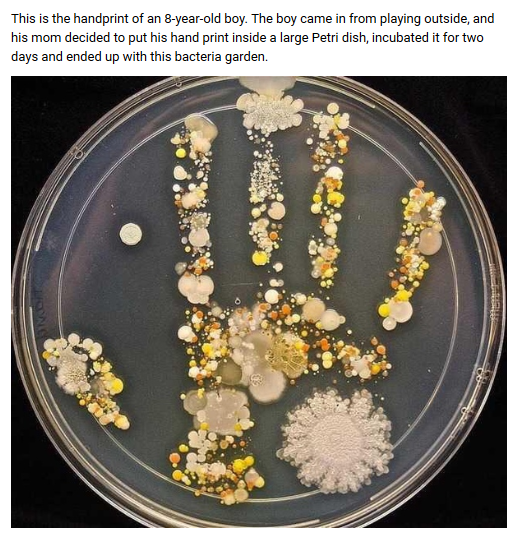
Fearless Rear tweet media

Sabitlenmiş Tweet
Fearless Rear
215 posts


Fearless Rear
@FearlessRear
Sustainability and personal hygiene seem to be too often contradictive concepts. Here shall at least in one area an alternative be offered and additional info.
Katılım Kasım 2018
1.4K Takip Edilen125 Takipçiler

Dr. Larry Palevsky tore down the premise from which immuno-compromised are alleged to benefit from. They can't.
Herd immunity and carpeting of protection is by principle & by medical evidence a falsity.
It'd be good to have all resources he referred to.
youtu.be/nT6I864vwbE

YouTube
English

UNIVERSITY OF WASHINGTON laid a tomb stone on Thomas Hobbes' vile legacy, that is summed up in his "homo homini lupus"; quoted from his "Leviathan"
washington.edu/news/2020/02/0…
nature.com/articles/s4159…
Here the PDF:
nature.com/articles/s4159…

English

This TWEET was found on FB first, just as it can be seen here. We thank @RitaMarie28 for bringing this to the world's attention.
@iPAHAM_PakAmeen, you are as teacher, coach and tutor as well part of this story; on Asian territory, but you sure understand what teachers sacrifice.
Fearless Rear@FearlessRear
This is a snippet from @LATimes, and it so much shows not only that AMERICA IS NOT GREAT AGAIN, but that there as well as around the world the RIGHT TO EDUCATION is despite it being part of DECLARATION OF HUMAN RIGHTS completely disregarded. The world society loses potentials.
English

This is a snippet from @LATimes, and it so much shows not only that AMERICA IS NOT GREAT AGAIN, but that there as well as around the world the RIGHT TO EDUCATION is despite it being part of DECLARATION OF HUMAN RIGHTS completely disregarded.
The world society loses potentials.

English
Fearless Rear retweetledi

Never underestimate the importance of #BIDET_SEATS.
Less than 5 months ago both wrists were fractured, the cleaning one worse than the other, which suffered from a traumatized elbow that still can't be straightened.
The nightmare of conscious 'sessions"
twitter.com/bestreviewstar…
English

@ondacobbles @MHRashman She might not have to use them anymore... that is the possible purpose of the brackets.
English

@MHRashman They’re only 35 years old, what’s up with you?
English

A very interesting read from SLATE:
slate.com/health-and-sci…
English
Fearless Rear retweetledi

This is the 1st TWEET that came up after a busy period that did not allow for TWITTER activity
Saddening that imperialism and colonialism haven't found an end. In many other world region this is done as well, under other labels, demonizing religious affiliation
#OneEarthPeople
Mani Isna La #IndigenousLivesMatter 🇨🇺🇵🇸🇬🇱@mikecoulson48
Indigenous women kept from seeing their newborn babies until agreeing to sterilization, says lawyer cbc.ca/radio/thecurre… Indigenous Women Were Forced Into Being Sterilized. Demand Justice! #care2 thepetitionsite.com/tell-a-friend/…
English

@Energy4L @biologyofbelief Loved already Dr. Bruce Lipton's insights on #EPIGENETICS, which had been compiled with someone's work on #FREQUENCY and #CYMATICS.
Since then we enjoy reflecting ever new over his (mainstream thought) challenging views.
English

Dr. Bruce Lipton @biologyofbelief explains the biophysical, electric nature of being human and what it means to our health and energy.
youtu.be/uCIgxYuNGu0
#biology #biophysics #bioinformatics #chienergy #energyforliving

YouTube
English
Fearless Rear retweetledi